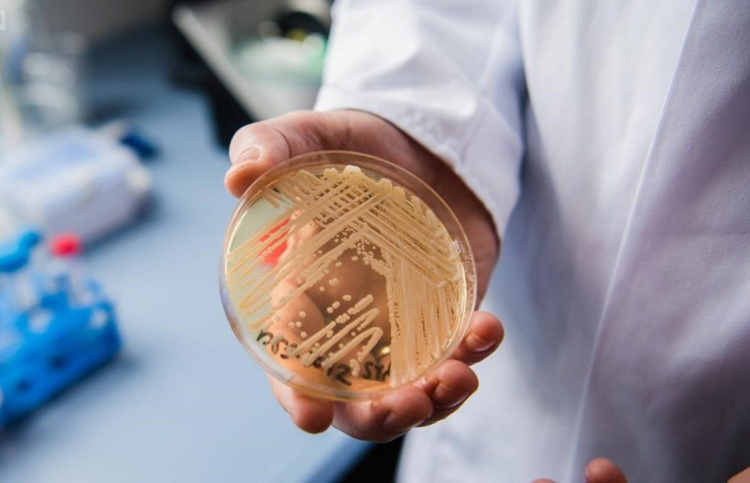
Alarma a Estados Unidos por Cándida Auris: un hongo mortal e intratable

El hongo altamente contagioso Candida auris se propaga a un ritmo alarmante en los Estados Unidos, según alertaron ayer lunes desde los Centros para el Control y la Prevención de Enfermedades (CDC, por sus siglas en inglés).
Se trata de un microorganismo particularmente peligroso porque resiste el tratamiento con los medicamentos antimicóticos más comunes. El patógeno se encuentra presente en más de 30 países y se había informado por primera vez en los Estados Unidos en 2016, en los estados de Nueva York e Illinois.
En la actualidad, según los CDC, se encuentra presente en más de la mitad de los 50 estados y ataca principalmente de personas mayores con sistemas inmunológicos debilitados.
Se informaron un total de 3.270 casos clínicos y 7.413 casos de detección de Candida auris en los Estados Unidos hasta el 31 de diciembre de 2021. El aumento porcentual de casos clínicos creció cada año, de un aumento del 44% en 2019 a un incremento del 95% en 2021.
El aumento es “dramático” en el número de casos y la transmisión, según un artículo de investigación publicado este lunes en Annals of Medicine y compilado por investigadores de los CDC.
Si bien el reciente documento no incluyó el número de casos de 2022, un sitio web de los CDC que rastrea la propagación del hongo muestra que se informaron 2.377 infecciones el año pasado, otro fuerte aumento en opinión de las autoridades sanitarias.
Propagación y mortalidad
Scott Roberts, especialista en enfermedades infecciosas de la Facultad de Medicina de Yale, si bien no participó en el nuevo estudio, advirtió que el aumento de la prevalencia y la resistencia a los medicamentos de Candida auris implica una grave amenaza para la salud.
“Creo que este problema no va a desaparecer. Creo que realmente sólo va a aumentar con el tiempo”, consideró, a la vez que remarcó: “A diferencia de otros hongos que normalmente se adquieren del medio ambiente, el Candida auris se propaga fácilmente de persona a persona”.
Y sumó: “Una vez que se instala, en un hogar de ancianos, por ejemplo, es casi imposible de erradicar. Así como cuando está en los pacientes, éstos pueden ser colonizados durante años, incluso durante toda su vida”.
En este punto, es importante destacar que según aseguraron las autoridades, el hongo “no se considera una amenaza para las personas sanas”. Sí advirtieron que “puede causar enfermedades graves y la muerte en personas que ya están enfermas, usan dispositivos médicos invasivos o tienen estadías prolongadas o frecuentes en los centros de atención médica”.
Hasta el momento, alrededor del 30% al 60% de las personas infectadas han muerto a causa del patógeno, aunque eso “se basa en información de un número limitado de pacientes”, aclararon desde los CDC.
En ese sentido, la epidemióloga del organismo Meghan Lyman sostuvo que “el rápido aumento y la propagación geográfica de los casos son preocupantes y enfatizan la necesidad de vigilancia continua, capacidad de laboratorio ampliada, pruebas de diagnóstico más rápidas y cumplimiento de la prevención y el control de infecciones comprobadas”.
¿Cómo saber si alguien está infectado?
Las personas que contraen infecciones invasivas por especies del género Candida generalmente ya están enfermas por otras afecciones, lo que dificulta saber si tienen una infección específicamente por Candida auris.
Los síntomas más comunes de una infección invasiva por especies del género Candida son: fiebre y escalofríos que no mejoran después de un tratamiento con antibióticos administrado por una presunta infección bacteriana.
Solo mediante una prueba de laboratorio se puede diagnosticar una infección por Candida auris. El organismo estadounidense recomendó consultar al médico si se cree que se tiene una infección micótica o asociada a la atención médica.